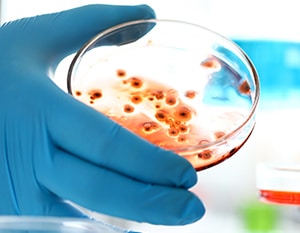
AGX Nordic arbetar med att lösa problem med mögel och radon i Norden

Svartmögel!
Är du en av många som har drabbats av svartmögel/mögelsvamp i hemmet? Det kan du mycket väl vara, för mögelsvampar växer och frodas nämligen riktigt bra i relativt fuktiga inomhusmiljöer. Och just fukten är tyvärr mycket vanlig i våra bostäder.
Så håll ett öga på ditt hem. Om du upptäcker gröna, svarta, bruna eller vita fläckar eller märken på väggar eller i taket någonstans i din bostad, då bör du omedelbart undersöka det.
Om AGX MögelTest /
AGX Nordic
AGX Nordic arbetar med att lösa problem med mögel och radon i Norden. AGX MögelTest erbjuder nya och prisvärda alternativ för mögeltestning och radontestning, så att du kan undvika hälsoproblem.
AGX Nordic är ett systerbolag till danska AGX Nordic ApS. Vårt huvudkontor och lager ligger i Glostrup, nära Köpenhamn i Danmark.
Våra utvalda produkter
Se hela vårt utbud-
Hot!
Hot!
PRO-Clean – snabbt mögeltest (minst 2 stycken)
Rabatt när du köper mer - ner till 110 kr. per styck. Med ett professionellt enzymtest, PRO-Clean snabbtest, kan du på bara 5 minuter ta reda på om du har ett område som är mögelfritt, eller om det har drabbats av mögelsvamp. I så fall kan du se hur omfattande angreppet är. Testet fungerar genom att mäta protein i mögelsvamp.129,00 kr -
Radondosor (minst 2 stycken)
Rabatt när du köper mer - ner till 245 kr. per styck. Med radondosor kan du snabbt och enkelt själv mäta radonnivån i hemmet. Tre enkla steg: 1. Beställ radondosor här. 2. Placera dosorna och mät sedan i 2-3 månader. 3. Skicka radondosorna i den bifogade kuvert. Du får svar direkt från laboratoriet. OBS! De angivna priserna är per styck!290,00 kr -
Hot!
Hot!
Mögel lufttest
Rabatt när du köper mer - ner till 329 kr. per styck. Med ett lufttest kan du enkel ta reda på om ditt hus drabbats av dolt svartmögel. När skålen är utplacerad kommer eventuella mögelsporer i luften bilda kolonier i plattan. Efter en timme är testet färdigt och efter fyra dagar får du reda på om det finns groningskraftiga mögelsvampar i huset och hur många. Du kan själv räkna hur många svampkolonier det finns. Om det finns 0–3 är luften fin. Om det finns mellan 4–6 har du lite högre halt än normalt. Om du har över 7 finns det för mycket mögel i luften. Mögel lufttestet bör användas så snart som möjligt efter att du har mottagit det.349,00 kr -
Enkel professionell fuktmätare
Mät enkelt och snabbt fuktnivån i material, och läs av fuktprocenten direkt på den stora färgskärmen. Mäter även temperatur och relativ luftfuktighet vid mätpunkten.1.590,00 kr -
Pico Pro+ 45 – väggmonterad ventilation med värmeåtervinning
Pico Pro+ 45 är en fläkt med värmeåtervinning, avsedd för användning i ett rum på upp till 41 m².6.490,00 kr






